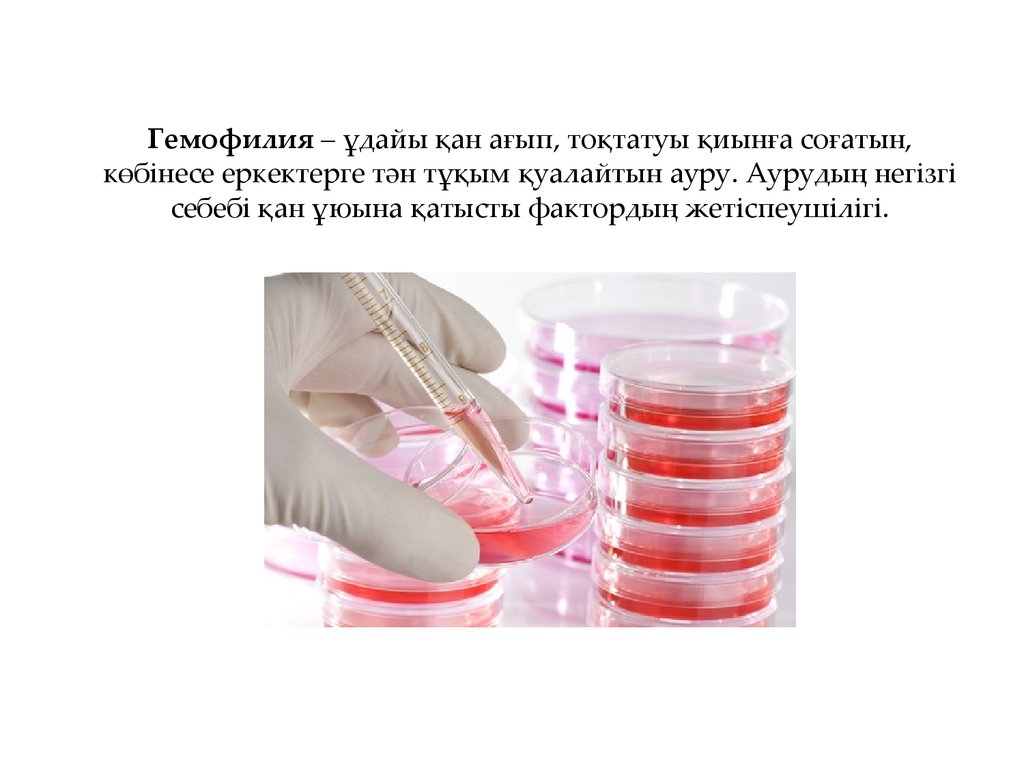
Гемофилия – ұдайы қан ағып, тоқтатуы қиынға соғатын, көбінесе еркектерге тән тұқым қуалайтын ауру. Аурудың негізгі себебі қан

Похожие презентации:
Гематологиялық аурулар
1. СӨЖ
С.Ж.АСФЕНДИЯРОВ АТЫНДАҒЫҚАЗАҚ ҰЛТТЫҚ МЕДИЦИНА
УНИВЕРСИТЕТІ
КАЗАХСКИЙ НАЦИОНАЛЬНЫЙ
МЕДИЦИНСКИЙ УНИВЕРСИТЕТ
ИМЕНИ С.Д.АСФЕНДИЯРОВА
СӨЖ
Тақырыбы: Гематологиялық
аурулар
Дайындаған: Сатинова З.Е
461-2
2. Жоспар:
Кіріспе
Гематологиялық аурулар
Гематологиялық аурулар түрлері
Қортынды
Дереккөздер
3. Кіріспе
Гематология(грек. haіma, haіmatos – қан және logos – ғылым) – қанжәне қан түзілу жүйесі, олардың құрылысы, қызметі, аурулары,
осы ауруды емдеу туралы ғылым;медицинаның бір саласы.
Гематология қан клеткалары мен қан жасаушы органдардың
эмбриогенезі,морфогенезі және олардың физиологиясының
мәселелерін, қан плазмасы мен сарысуының қасиеттерін,
Гематологияға жатпайтын аурулардағы қан түзілуінің
өзгерістерін зерттейді. Қазақстандағы Гематология саласындағы
зерттеулер 1960жылдан бастап жүргізілді
4. Гематологиялық аурулар
Гематологиялық аурулары:• Агранулоцитоз
• Анемия
• Сарысу
• Гемофилия
• Лейкемия
• Тромбоцитопения
5.
Агранулоцитоз – Шеткері қантамырларында түйір лейкоциттердің азаюы.
Организмнің дірілге, химиялық заттарға
ерекше сезімталдығынан пайда болады.
6.
Анемия – қан аздығы; ауырған адамның қаны сұйылып кетеді, бұлаурудың сипаты ағза қан қалыақа келтіріп үлгергенше қанның
азайып немесе жойыла бастауымен байланысты айқындалады.
Үлкен жарақаттар алғанда, аузы ашылып кеткен асқазан
жарасы, іщ сүзегі негізіндегі канның тоқтамауы адамды анемия
ауруына шалдықтыруы мүмкін.
7. Сарысу ауруы - көптеген маңызды орган заттар бар қан таза сұйық бөлігі. Иммундық жауап барысында иммуноглобулин , инфекцияға
қарсы қорғауға көмектеседі ақуыздардысинтезделеді. Белоктар көптеген арасында бірегей антидене
( арнайы , мысалы, қарсы қызамық сияқты , жұқтыру белгілі бір
түріне шешу үшін құрылған молекула ) өз құрылымында бар.
8. Гемофилия – ұдайы қан ағып, тоқтатуы қиынға соғатын, көбінесе еркектерге тән тұқым қуалайтын ауру. Аурудың негізгі себебі қан
ұюына қатысты фактордың жетіспеушілігі.9.
Лейкемия - қан түзетін органдар жүйесінің қатерлі ісіктері.
Ісік жілік майындағы клеткалардың тоқтаусыз өсуімен және сол
жердегі қалыпты қан жасалу процесінің бұзылуымен
сиппатталады. Соның нәтижесінде қан түйіршіктерінің саны
азайып, ал жетілмеген лейкоциттер саны көбейіп кетеді.
10.
Тромбоцитопения қандағы тромбоциттер саны патологиялық
төмендеуі болып анықталады. Тромбоциттер ұюы үшін жауапты
арнайы ұяшықтар болып табылады. Олар қан тоқтатуға қатысады.
Тромбоциттер қызметі: фибринолиз – ұйыған қанды еріту, және қан
ұю үрдістіріне белсене қатысады.
11.
ҚорытындыГематологиялық аурулар белгілері балаларда, жасөспірімдерде
біліне бастағаннан-ақ міндетті түрде тәжірибелі дәрігер
маманға көрсетуіңіз қажет. Бұл ауру оте күрделі ауру болып
табылады. Дер кезінде комек корсетпесе олімге алып келуы
мүмкін.
12.
ДереккөздерБиоморфология терминдерінің түсіндірме сөздігі/ - Алматы:
"Сөздік-Словарь", 2009.
Строев Ю. И. Гематологиялық аурулар и др.: . СПб, 1992
Үй-тұрмыстық энциклопедиясы. Алматы : Қаз.Сов.энцикл.Бас
ред., 1990
Вернер, Дэвид. Халыққа медициналық жәрдем көрсету жөніндегі
(Анықтамалық). Қазақ тіліне аударғандар: Айымбетов М,
Бермаханов А.—Алматы: "Демалыс", "Қазақстан", 1994— 506
бет.
http://referatkaz.kz/endokrindik-zhyjesinin-patofiziologiyasy/
http://kazmedic.kz/archives/1128
http://referat-kz.kz/referattar/biologiya/54-ant-diabetn-trler.html

Медицина
Медицина








